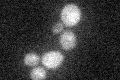
YPL055C
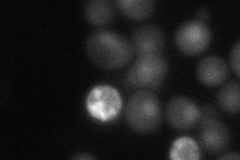
YPL055C
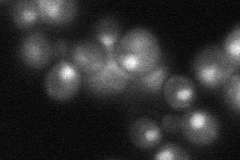
YPL055C

View description
Protein of unknown function; null mutant forms abnormally large cells, and homozygous diploid null mutant displays delayed premeiotic DNA synthesis and reduced efficiency of meiotic nuclear division
Localization:
Intensity:
Fold change:
Significance:
-
C’ GFP library in SD
below threshold15.66 -
N' NOP1pr-GFP in SD

nucleus40.8007 -
N' TEF2pr-mCherry in SD
nucleus29.2579 -
N' NATIVEpr-GFP in SD
nucleus36.532 -
N' TEF2pr-VC and Cyto-VN in SD

below threshold30.1748 -
C’ GFP library in SD+DTT

cytosol13.270.84No -
C’ GFP library in SD+H2O2

cytosol18.071.15No -
C’ GFP library in Starvation Media

cytosol18.291.16No -
C’ GFP library on the background of Pup2-DaMP

below threshold -
C’ GFP library on the background of CCT mutant

below threshold16.4841.05197No
